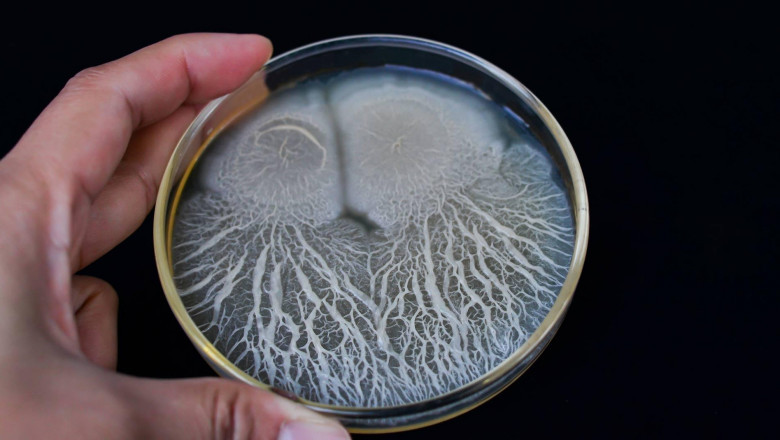
Bacillus Subtilis Is Commonly Used As A Fungicide On Crops To Fight Fungal Diseases

views
Bacillus subtilis, often known as hay bacillus or grass bacillus, is a Gram-positive, catalase-positive bacteria that can be found in soil, ruminants' gastrointestinal tracts, and marine sponges' gastrointestinal tracts. B. Bacillus subtilis advantages include better digestive health and IBS symptoms, immune system function, and fat metabolism as a member of the Bacillus genus. The benefits of soil-based probiotics aren't limited to the gastrointestinal tract. Bacillus subtilis and other probiotics found in soil are harmless (in spite of some controversy). This product is unlikely to cause a severe allergic reaction. However, if you detect any symptoms of a major allergic response, such as a rash, itching/swelling (particularly of the face/tongue/throat), extreme dizziness, or problems breathing, seek medical attention right once. This isn't an exhaustive list of potential adverse effects.
Read More @ https://expressmyblog.blogspot.com/2022/06/bacillus-subtilis-has-significant-use.html












